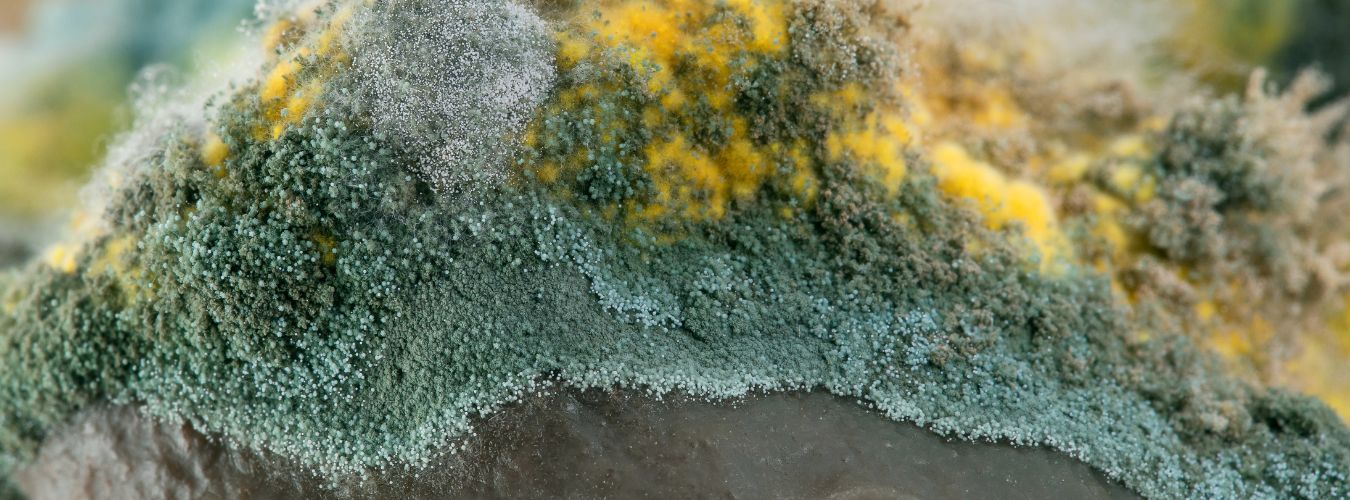

Module 4: Wet- en regelgeving
4.4 Overige dierenwetgeving – van uithuisplaatsing tot proefdieren
Naast de Wet dieren en de Omgevingswet zijn er verschillende andere wetten en regelgevingen die relevant zijn voor gemeenten met betrekking tot dieren.
Deze wetten gaan onder andere over de bescherming van wilde dieren, dierproeven, visserij, volksgezondheid, etc. Zoals eerder gezegd: ongeveer de helft van de Nederlandse wetgeving op het gebied van dieren komt tot stand uit Europese verdragen. Deze worden ook in deze les verder uitgewerkt.
Burgerlijk Wetboek (BW) – Opvang van zwervende dieren en dierbezit
Burgerlijk Wetboek (BW) – Opvang van zwervende dieren en dierbezit
Relevante artikelen:
- Artikel 5:8 lid 3 BW – Bewaarplicht voor gevonden huisdieren.
- Artikel 19 BW – Verlies van eigendom bij verwildering of achterlating.
- Artikel 23 BW – Verwijderen van dieren op andermans terrein en schadevergoeding.
Wat houdt de wet in?
Het Burgerlijk Wetboek bepaalt hoe moet worden omgegaan met gevonden dieren en verloren eigendom:
- Bewaarplicht: gemeenten zijn verplicht gevonden huisdieren 14 dagen op te vangen, zodat eigenaren de kans hebben ze op te halen. Na deze termijn mag de gemeente het dier herplaatsen of, als dat niet mogelijk is, laten inslapen.
- Verlies van eigendom: als een tam dier verwildert of een eigenaar niet direct een ontsnapt dier terughaalt, verliest hij juridisch gezien zijn eigendomsrecht.
- Dieren op andermans terrein: als een dier onbedoeld op privéterrein terechtkomt, moet de eigenaar van het dier toestemming krijgen om het dier op te sporen. Eventuele schade moet worden vergoed.
Wat gebeurt er als een huisdier wordt gevonden? (Artikel 5:8 lid 3 BW)
Volgens artikel 5:8 lid 3 BW is de gemeente verplicht een gevonden huisdier met een vermoedelijke eigenaar 14 dagen in bewaring te houden. Tijdens deze periode heeft de oorspronkelijke eigenaar de kans om zijn dier terug te halen. Dit heeft de volgende gevolgen:
Opvangverantwoordelijkheid van de gemeente
De gemeente moet zorgen dat gevonden huisdieren ondergebracht worden in een opvanglocatie. Nodig hiervoor is een contract met de dierenambulance en een asiel. In die periode van twee weken is de gemeente (de burgemeester) eigenaar van het dier.
Registratie en opsporing eigenaar
Tijdens de bewaartermijn moet worden geprobeerd de eigenaar te traceren, bijvoorbeeld via chipregistratie of via de social media van het asiel.
Na 14 dagen
Als de eigenaar zich niet meldt, mag de gemeente besluiten het dier over te dragen aan een nieuw baasje, bij het asiel te laten of – in uitzonderlijke gevallen – het dier te laten inslapen. Door als gemeente te werken met een machtiging waarbij de burgemeester bevoegdheden overdraagt aan het asiel, kan het asiel direct actie ondernemen zonder voor elk dier overleg te moeten voeren met de gemeente. Wel draait de gemeente op voor de kosten voor die twee weken zorg en opvang.
Uitzonderingen op de bewaartermijn
Als het dier ernstig ziek is of de opvang onevenredig hoge kosten met zich meebrengt, kan worden afgeweken van de 14-dagenregel. Het dier wordt dan ingeslapen maar nog wel 14 dagen bewaard voor het geval de eigenaar zich alsnog meldt.
Wat gebeurt er als een dier wordt achtergelaten? (Artikel 19 BW)
Volgens artikel 19 BW verliest een eigenaar het eigendomsrecht op een dier als het wordt achtergelaten en de eigenaar geen pogingen onderneemt om het dier terug te halen. Dit heeft betrekking op dumpingen bijvoorbeeld. Kippen, hanen en konijnen worden vaak buitengezet op deze manier. Dit heeft de volgende gevolgen:
Verlies van eigendom
Zodra een eigenaar een dier opzettelijk in de steek laat, wordt het dier juridisch gezien als ‘res nullius’ (een onbeheerd goed). De eigenaar kan geen aanspraak meer maken op het dier en het eigendom gaat over op de burgemeester.
Beslissingsrecht van de burgemeester
De burgemeester heeft de bevoegdheid om te bepalen wat er met het dier gebeurt. Dit kan betekenen dat het dier ondergebracht wordt in een opvangcentrum of asiel, waar het herplaatst kan worden. Het dier kan ook overgedragen worden aan een nieuwe eigenaar (als het herplaatsbaar is) of in uiterste gevallen wordt het dier geëuthanaseerd (bijvoorbeeld als het dier ernstig ziek of gewond is en medische behandeling niet haalbaar is).
Wat gebeurt er als een dier zich op andermans terrein bevindt? (Artikel 23 BW)
Volgens artikel 23 BW heeft de eigenaar van een dier het recht om zijn dier op te sporen en terug te halen als het zich op andermans terrein bevindt. De eigenaar van het terrein moet dit toestaan, maar kan wel eisen dat eventuele schade die door het dier is veroorzaakt, wordt vergoed. Dit heeft de volgende gevolgen:
Verplichtingen van de grondeigenaar
De eigenaar van de grond moet toestaan dat de diereneigenaar het dier terughaalt, tenzij er sprake is van overlast of gevaar.
Schadevergoeding
Als het dier schade aanricht aan gewassen, gebouwen of andere eigendommen, kan de eigenaar van het terrein een schadevergoeding eisen.
Retentierecht
De grondeigenaar kan het dier vasthouden totdat de schadevergoeding is betaald.
Dit artikel in de wet kan voor heftige burenruzies zorgen: stel dat een kat van de buren in de tuin alle nieuwe planten uitgraaft en daar zijn ontlasting doet. Volgens dit artikel mag de grondeigenaar (de eigenaar van de betreffende tuin) de kat vasthouden tot dat de eigenaar van de kat de vergoeding van de plantjes betaalt. Als deze dit weigert te doen, dan mag de kat ‘in gijzeling’ worden gehouden. Met als gevolg: een grote burenruzie, waarschijnlijk betrokkenheid van de politie, etc.

Algemene wet bestuursrecht (Awb) - Huisontruimingen
Algemene wet bestuursrecht (Awb) – Huisontruimingen
Bij huisontruimingen is de gemeente verantwoordelijk voor het beheer van achtergelaten inboedel. Ook huisdieren vallen onder inboedel. Deze verantwoordelijkheid is vastgelegd in de Algemene wet bestuursrecht (Awb), specifiek in artikel 5:29 en artikel 5:30.
Wat houden deze artikelen in?
- Artikel 5:29 Awb
Dit artikel bepaalt dat een bestuursorgaan, zoals de gemeente, bij de toepassing van bestuursdwang zaken kan meevoeren en opslaan. Dit betekent dat wanneer een woning wordt ontruimd, de gemeente de achtergebleven eigendommen, waaronder huisdieren, moet afvoeren en opslaan. - Artikel 5:30 Awb
Hierin is vastgelegd dat de gemeente de opgeslagen zaken gedurende maximaal 13 weken moet bewaren. Binnen deze periode kan de eigenaar zijn eigendommen terugvorderen. Na deze termijn is de gemeente bevoegd om de zaken te verkopen, over te dragen of te vernietigen. Voor dieren betekent dit dat, indien de eigenaar zich niet meldt binnen 13 weken, de gemeente kan besluiten het dier over te dragen aan een dierenasiel of, in uiterste gevallen, euthanasie te laten uitvoeren. - Artikel 3:4 Awb (evenredigheidsbeginsel)
Schrijft voor dat bestuursorganen een redelijke afweging moeten maken tussen het doel en de lasten die daaruit voortvloeien. - Artikel 5:25 lid 3 Awb (kostenverhaal bij bestuursdwang)
Stelt dat de overtreder betaalt de kosten van bestuursdwang, tenzij dit onredelijk is. De eigenaar van het dier is dus verantwoordelijk voor de kosten. Het geeft de gemeente de mogelijkheid om van opslag af te zien als de kosten onevenredig hoog zijn in verhouding tot de waarde van de zaken. Met andere woorden: een Ikea kastje van 10 euro ga je niet opslaan als de opslagkosten 50 euro per week zijn. - Dieren vallen niet onder de reguliere regelgeving voor inboedel, omdat ze juridische bescherming genieten op basis van het Burgerlijk Wetboek (artikel 3:2a BW): “Dieren zijn geen zaken.”
Hoe het geregeld is in wet
De gemeente moet bij een huisontruiming zorgen voor de opvang en verzorging van achtergelaten huisdieren gedurende 13 weken. Dit houdt in dat de dieren op een geschikte locatie worden ondergebracht waar ze de nodige zorg ontvangen (asiel). De kosten voor de opvang en verzorging van de dieren gedurende deze periode zijn voor rekening van de gemeente. Deze kosten kunnen later op de eigenaar worden verhaald.
Hoe het werkt in de praktijk
Helaas is bij huisontruimingen in de meeste gevallen geen eigenaar meer te achterhalen. Officieel geldt een wettelijke bewaartermijn van 13 weken waarin de eigenaar zich kan melden, maar deze periode brengt aanzienlijke kosten met zich mee voor het asiel, zeker omdat deze dieren vaak een medische achterstand hebben. Daarnaast is een langdurige opvang niet in het welzijn van het dier, omdat drie maanden in een asielomgeving kan leiden tot stress en welzijnsproblemen.
Om dit te voorkomen, wordt in de praktijk vaak afgestemd tussen het asiel, de gemeente en eventueel de deurwaarder of woningbouwvereniging over een afstandsverklaring. Via een contract kan de gemeente na drie weken het eigenaarschap van het dier overdragen aan het asiel, zodat het dier sneller kan worden herplaatst. Dit biedt zowel een diervriendelijkere oplossing als een beheersbare kostenstructuur.
In veel gevallen is de 13 weken bewaartermijn niet expliciet geregeld in de afspraken tussen gemeente en asiel, wat leidt tot onduidelijkheid over wie verantwoordelijk is voor de kosten en of deze op de eigenaar verhaald kunnen worden. Omdat langdurige opvang zowel financieel als qua dierenwelzijn ongunstig is, is het essentieel dat gemeenten en asielen hier duidelijke afspraken over maken en deze vastleggen in een contract.
Euthanasie mag alleen worden overwogen als dieren ernstig lijden of een direct gevaar vormen. Kosten mogen hier geen doorslaggevende factor zijn.
Praktijkvoorbeeld
Bij een huisontruiming treft de gemeente een kat en een hond aan die door de bewoner zijn achtergelaten. Conform de Awb worden deze dieren overgebracht naar een lokaal dierenasiel.
Het asiel constateert dat de dieren ernstig verwaarloosd zijn. De kosten lopen op voor hun verzorging. De woningbouwvereniging heeft laten weten dat er geen mogelijkheden zijn om verder in contact te komen met de eigenaar en dat daar ook geen kosten te verhalen zijn. De gemeente en het asiel hebben in een overeenkomst vastgelegd dat de gemeente, bij het ontbreken van een eigenaar, na een termijn van drie weken de zorg en eigendomsrechten overdraagt aan het asiel. Het asiel wordt hiermee de eigenaar van deze dieren en kan overgaan tot herplaatsing. De gemeente en de woningbouwvereniging betalen beide 50% van de kosten voor een verblijf van drie weken inclusief medische kosten.

Wetgeving bij opname van eigenaar
Wetgeving bij opname van eigenaar
In Nederland is er geen specifieke wet die regelt wie de zorg voor achtergebleven huisdieren op zich neemt wanneer iemand wordt opgenomen in een ziekenhuis, GGZ-instelling of gevangenis. De verantwoordelijkheid voor deze dieren wordt doorgaans als volgt geregeld:
1. Opname in een ziekenhuis of GGZ-instelling
- Eigen verantwoordelijkheid
De patiënt is in eerste instantie zelf verantwoordelijk voor het regelen van de zorg voor zijn of haar huisdieren bij een (onverwachte) opname. - Familie en vrienden
Vaak nemen familieleden, vrienden of buren de zorg tijdelijk over. - Gemeente
Wanneer er geen direct netwerk beschikbaar is, kan de gemeente ingeschakeld worden. Sommige gemeenten hebben afspraken met dierenasielen of -opvangcentra om tijdelijk voor de dieren te zorgen. Als er hulpdiensten betrokken zijn bij de opname (politie, ambulance), dan zorgen zij er vaak voor dat een dier naar het asiel wordt gebracht. Omdat niet duidelijk is hoelang iemand opgenomen moet worden en of de zorg voor het dier daarna nog plaats kan vinden, levert dit grote onzekerheden op. Een afstandsverklaring bij een mogelijke opname voor langere duur is dan te overwegen áls er iemand is die voor de eigenaar verantwoordelijk is.
2. Opname in een gevangenis
- Vooraf regelen
Bij een geplande detentie wordt van de persoon verwacht dat hij of zij vooraf de zorg voor huisdieren regelt. - Onverwachte detentie
Bij een onverwachte arrestatie kan de politie contact opnemen met familie of vrienden om voor de dieren te zorgen.
Als dit niet mogelijk is, kan de dierenopvang worden ingeschakeld. Ook hiervoor geldt dat de onzekerheid groot is of iemand weer voor het dier kan gaan zorgen en zo ja, per wanneer. Vooral bij langere detentie levert het hoge kosten op voor het asiel en ook vanuit dierenwelzijn is een langdurige opsluiting van het dier niet aan te raden. Ook hier zou een afstandsverklaring een uitkomst bieden, als de eigenaar van het dier hier aan mee wil werken. - Rol van de gemeente
Hoewel er geen specifieke wet is die deze situaties regelt, hebben gemeenten de plicht om te zorgen voor achtergebleven dieren binnen hun jurisdictie. Dit valt onder hun algemene zorgplicht voor dierenwelzijn.
Gedwongen opnames, of dat nu in een ziekenhuis of gevangenis is, leveren kopzorgen op voor allerlei instanties: politie die de dieren vaak aantreft en probeert in contact te komen met familie of vrienden om de zorg voor het dier over te nemen, het asiel die in onzekerheid zit over de periode waarin het dier opgevangen moet worden en waar de kosten verhaald kunnen worden. Er zijn al hulpdiensten die werken met een afstandsverklaring, waarbij de eigenaar direct bij hechtenis/opname, moet tekenen voor het afstaan van zijn/haar dier. Dit is niet conform wetgeving, maar uit de praktijk blijkt het wel regelmatig de beste oplossing voor alle partijen. Voor asielen is er wel een extra zorg: wat als een dier ter adoptie is aangeboden en de eigenaar komt na een paar weken/maanden (of zelfs jaren) terug om zijn/haar dier op te halen?

Dierproeven en proefdieren
Dierproeven en proefdieren
Binnen je werk kun je te maken krijgen met bedrijven binnen jouw gemeente die zich bezig houden met wetenschappelijk onderzoek en daarvoor dierproeven uitvoeren. Hoewel dit vanuit EU en landelijke wetgeving is geregeld, kunnen er wel vragen en bezwaren binnen komen bij een gemeente.
Europese richtlijn en verordening voor dierproeven
Binnen de EU zijn de volgende richtlijnen/verordeningen van kracht als het gaat om het gebruiken van dieren voor dierproeven:
1. Richtlijn 2010/63/EU inzake de bescherming van dieren die voor wetenschappelijke doeleinden worden gebruikt.
Basisregelgeving binnen de EU voor het gebruik van proefdieren. 3V-principe: Vervanging, Vermindering, Verfijning.
Lidstaten zijn verplicht nationale wetgeving hierop af te stemmen.
2. Verordening (EG) nr. 1223/2009 (Cosmetica Verordening)
Verbod op dierproeven voor cosmetica in de EU. Geen verkoop van producten die op dieren zijn getest buiten de EU toegestaan.
3. Verordening (EU) 2019/1010 (Controle en rapportage wetgeving milieu)
Transparantie en rapportage over het gebruik van dierproeven binnen milieuwetgeving.
Nederlandse wetgeving
Wet op de dierproeven (WOD)
Dit is de Nederlandse implementatie van de Europese richtlijn en bepaalt onder welke voorwaarden dierproeven mogen worden uitgevoerd. De wet vereist een vergunning en naleving van de ‘3V’s’: Vervanging, Vermindering en Verfijning.
Regelt onder welke voorwaarden dierproeven mogen worden uitgevoerd. De Centrale Commissie Dierproeven (CCD) beoordeelt en verleent vergunningen.
Wet dieren – artikel 10.6: dierproeven
Artikel 10.6 bevestigt dat de Wet op de dierproeven leidend blijft bij dierproeven en dat de Wet dieren daar niet in ingrijpt, behalve bij enkele specifieke artikelen over dierenwelzijn. Daarnaast maakt het duidelijk dat dierproeven geen diergeneeskundige handelingen zijn, zodat deze onder een aparte vergunningensystematiek vallen.
De artikelen uit de Wet dieren die aanvullend zijn op de Wet op de dierproeven (WOD):
- Het welzijn van dieren wordt beschermd door te eisen dat alleen bepaalde diersoorten worden gebruikt, gevaarlijke dieren worden gereguleerd en noodzakelijke verzorging wordt geboden.
- Er mag niet worden gefokt met dieren met genetische afwijkingen of gezondheidsproblemen.
- Biotechnologische handelingen met dieren, zoals genetische modificatie voor onderzoeksdoeleinden, mogen alleen met de juiste vergunningen worden uitgevoerd, wat extra waarborgen biedt voor het dierenwelzijn tijdens dierproeven.
Dierproevenbesluit en Dierproevenregeling
Deze besluiten geven verdere details over de uitvoering van de Wet op de dierproeven. Hierin staat onder andere hoe instellingen met dierproeven moeten omgaan en hoe inspecties worden uitgevoerd.
De rol van de gemeente
Hoewel dierproeven voornamelijk onder landelijke en EU-regelgeving vallen, hebben gemeenten indirecte verantwoordelijkheden:
Ruimtelijke ordening en vergunningen
Gemeenten kunnen via omgevingsvergunningen beperkingen opleggen aan instellingen die dierproeven uitvoeren. In bestemmingsplannen kan rekening worden gehouden met de vestiging van proefdiercentra.
Dierenwelzijnsbeleid
Gemeenten kunnen beleid voeren dat dierproeven ontmoedigt door te investeren in alternatieve onderzoeksmethoden. Bewustwordingscampagnes en educatie.
Handhaving en toezicht
Gemeentelijke handhavers kunnen signalen van overtredingen doorgeven aan de NVWA.

Kaderrichtlijn Water
Kaderrichtlijn Water en de impact op dieren
De Kaderrichtlijn Water (KRW) is een Europese richtlijn die normen stelt voor waterkwaliteit en de bescherming van aquatische ecosystemen. De richtlijn is in Nederland geïmplementeerd en verankerd in de nationale wetgeving, met name in de Omgevingswet en het Besluit kwaliteit leefomgeving (Bkl). Doel van de KRW is het beschermen en verbeteren van de waterkwaliteit van zowel oppervlaktewater als grondwater. Dit heeft ook gevolgen voor dieren die in of rondom water leven.
Gevolgen voor dieren
- Botulisme en massale sterfte van watervogels en vissen: botulisme is een bacteriële infectie die optreedt bij warm weer en stilstaand water met een hoog gehalte aan organisch materiaal. Dit kan leiden tot massale sterfte onder watervogels en vissen.
- Lozingen van gif en chemicaliën: illegale of onbedoelde lozingen van chemicaliën, mest of andere verontreinigingen kunnen toxische effecten hebben op waterdieren en vogels die van dat water drinken.
- Poep van watervogels en impact op waterkwaliteit: grote concentraties van watervogels kunnen leiden tot een verhoogd gehalte aan voedingsstoffen in het water, wat kan resulteren in zuurstoftekort en blauwalgproblemen, met sterfte van vissen en andere aquatische dieren als gevolg.
Impact op de gemeente
- Preventieve maatregelen tegen botulisme: gemeenten moeten in samenwerking met waterschappen en natuurbeheerders zorgen voor een goede doorstroming en zuurstofgehalte van stilstaande wateren. Goede afstemming van wie welk water is, is dus belangrijk. Ook als het een water is van een waterschap maar er bijvoorbeeld een fontein in staat van de gemeenten die voor de doorstroming/beweging in het water zorgt.
- Handhaving van lozingsregels: de gemeente werkt samen met de omgevingsdienst, politie en handhaving voor de toezicht op illegale lozingen.
- Beheer van watervogelpopulaties: door bijvoorbeeld voederverboden en nestbewerking in te stellen kan de gemeente overmatige concentraties van vogels in bepaalde watergebieden voorkomen.
De Richtlijn stedelijk afvalwater stelt regels voor de lozing van afvalwater ter bescherming van de volksgezondheid en waterkwaliteit. Gemeenten hebben hierbij een taak in het beheer van rioleringen en de behandeling van afvalwater om vervuiling van oppervlaktewater te voorkomen.
Praktijkvoorbeeld
In een stadspark melden bewoners dat dode eenden en vissen in het water drijven. De gemeente onderzoekt samen met het waterschap de oorzaak en constateert een botulisme-uitbraak. Als maatregel worden waarschuwingsborden geplaatst en dode dieren snel opgeruimd om verdere verspreiding van de bacterie te voorkomen. Tevens worden luchtpompen ingezet om het zuurstofgehalte in het water te verhogen.
Benelux-regelgeving over jacht en vogelbescherming
Benelux-regelgeving over jacht en vogelbescherming
De Benelux-regelgeving over jacht en vogelbescherming stelt regels vast voor de jacht en de bescherming van trekvogels binnen België, Nederland en Luxemburg. De nadruk ligt op het voorkomen van illegale jacht en het beschermen van vogelsoorten die door meerdere landen migreren. De Benelux-samenwerking speelt hierin een belangrijke rol door harmonisatie van regelgeving, zodat vogels niet in het ene land worden beschermd en in het andere land worden bejaagd.
Impact op de gemeente
- Controle op vergunningen voor jachtactiviteiten binnen de gemeente.
- Handhaving van regelgeving rond vogelbescherming, zoals verstoring van nesten in het broedseizoen.
- Samenwerking met jachtverenigingen (WBE) en natuurorganisaties.
Europese exotenregelgeving
Europese exotenregelgeving: aanpak van invasieve uitheemse soorten
Invasieve uitheemse diersoorten vormen een bedreiging voor biodiversiteit, ecosystemen en inheemse diersoorten. De Europese exotenregelgeving, vastgelegd in Verordening (EU) nr. 1143/2014, stelt regels voor het bezit, de handel, kweek en introductie van invasieve soorten. Deze verordening is direct van toepassing in alle EU-lidstaten en verplicht nationale overheden tot maatregelen om schadelijke soorten te bestrijden en verdere verspreiding te voorkomen.
Aanvullende wetgeving die impact heeft op exotenbeheer
1. Verordening (EU) nr. 1143/2014 (EU-exotenverordening)
Bevat een Unielijst van invasieve exoten, waarvoor bezit, handel, kweek, transport en uitzetting verboden zijn. Lidstaten moeten maatregelen nemen om de verspreiding van deze soorten te voorkomen, beheersen en uitroeien.
2. Uitvoeringsverordening (EU) 2016/1141
Lijst van verboden invasieve exoten, zoals de wasbeer, Amerikaanse rivierkreeft, roodwangschildpad en muntjak. Lidstaten moeten rapporteren over hun aanpak en populatiebeheer.
3. Omgevingswet
o Nederlandse uitwerking van de EU-verordening: de provincies zijn verantwoordelijk voor het beheer en bestrijding van invasieve exoten.
Gemeenten kunnen provinciale maatregelen aanvullen met lokaal beleid en handhaving.
4. Waterwet en samenwerking met waterschappen
Waterschappen beheren waterlichamen en zijn betrokken bij bestrijding van invasieve waterdieren zoals de Amerikaanse rivierkreeft. Gemeenten en waterschappen werken samen om waterkwaliteit en biodiversiteit te beschermen.
Impact op de gemeente
- Beheer en bestrijding van invasieve exoten: gemeenten nemen maatregelen in stadsparken, wateren en natuurgebieden om populaties te beheersen.
- Samenwerking met waterschappen en provincies: integrale aanpak om schade aan ecosystemen te beperken.
- Informatie en handhaving: gemeenten kunnen inwoners voorlichten over verboden exoten en overtredingen melden bij de omgevingsdienst of provincie.
Europese zeehondenregelgeving
Europese zeehondenregelgeving: verbod op handel in zeehondenproducten
De Europese zeehondenregelgeving, vastgelegd in Verordening (EG) nr. 1007/2009, stelt een verbod op de handel in zeehondenproducten binnen de Europese Unie. Dit verbod is ingevoerd om wrede vangstmethoden tegen te gaan en de jacht op zeehonden te ontmoedigen. De regelgeving heeft als doel dierenwelzijn te beschermen en voorkomt dat zeehondenbont en -olie op de Europese markt terechtkomen.
Er geldt een algemeen verbod op de handel, invoer en export van zeehondenproducten binnen de EU. Uitzonderingen gelden voor producten afkomstig van de traditionele jacht door Inuitgemeenschappen en voor producten gebruikt voor wetenschappelijke doeleinden.
In Nederland is de handhaving van dit verbod belegd bij de NVWA. Handelaren en importeurs moeten aantonen dat hun producten niet onder het verbod vallen. De douane controleert de invoer van producten en kunnen verdachte partijen in beslag nemen.
Habitatrichtlijn
Habitatrichtlijn: bescherming van natuur en biodiversiteit
De Habitatrichtlijn (Richtlijn 92/43/EEG) is een Europese richtlijn die tot doel heeft de bescherming van natuurlijke habitats en bedreigde diersoorten binnen de EU te waarborgen. De richtlijn is in Nederland geïmplementeerd via de Omgevingswet en bepaalt dat bij ruimtelijke ontwikkelingen en natuurbeheer rekening moet worden gehouden met kwetsbare ecosystemen en beschermde diersoorten.
Impact op de gemeente
- Beoordelen van vergunningaanvragen: gemeenten moeten bij ruimtelijke ontwikkelingen toetsen of er gevolgen zijn voor beschermde natuur. Dit geldt vooral in en rondom Natura 2000-gebieden.
- Natuurcompensatie en mitigatie: bij onvermijdelijke aantasting van natuur moet de gemeente maatregelen nemen om dit te compenseren, zoals het aanleggen van nieuwe natuurgebieden of ecoducten.
- Handhaving van natuurbescherming: gemeenten moeten toezien op naleving van regels voor soortenbescherming en ingrepen in natuurgebieden.
Wildklemverordening
Wildklemverordening
Deze Europese verordening beperkt het gebruik van vallen en klemmen voor het vangen of doden van dieren. De wet is bedoeld om onnodig dierenleed te voorkomen en selectiever beheer mogelijk te maken.
Impact op de gemeente
- Toezicht houden op het gebruik van vangmiddelen in natuurgebieden en stedelijke gebieden.
- Bewustwording creëren bij inwoners over het verbod op bepaalde soorten vallen en klemmen.
- Samenwerking met natuurorganisaties en handhavingsinstanties om overtredingen te signaleren.

De Nederlandse en Europese wetgeving rondom dierenwelzijn en natuurbeheer is breed en raakt aan verschillende aspecten, van de opvang van achtergelaten huisdieren tot het beheer van wilde dieren en invasieve exoten. In jouw werk kun je te maken krijgen met hele specifieke vragen hierover.
Je hoeft niet alle wetten daarvoor paraat te hebben, maar met deze les krijg je wel meer inzicht in de uitgebreidheid ervan. Belangrijk om daarbij te weten is dat veel vanuit EU verband wordt opgesteld, dat Nederland aanvullende regels kan hebben en waar een gemeente wel of niet verantwoordelijk voor is.

Praktijkvoorbeeld: gemeentebeleid rondom dierproeven
In de gemeente is een groot bio-life science park gevestigd, waar diverse bedrijven zich bezighouden met biomedisch onderzoek. Sommige bedrijven voeren dierproeven uit, wat leidt tot politieke en maatschappelijke discussie. De gemeenteraad heeft technische vragen gesteld of het mogelijk is om deze dierproeven te stoppen.
De wethouder heeft de beantwoording hiervan bij jou gelegd. Hoe pak je dit aan?
Uitwerking hieronder
Mogelijk advies
1. Wettelijke kaders en bevoegdheden van de gemeente
- Leg uit dat dierproeven vallen onder landelijke en Europese wetgeving (zoals de Wet op de dierproeven en de Richtlijn 2010/63/EU) en dat een gemeente geen directe bevoegdheid heeft om deze te verbieden.
- Benadruk dat vergunningen voor dierproeven worden verleend door de Centrale Commissie Dierproeven (CCD) en dat het toezicht ligt bij de Nederlandse Voedsel- en Warenautoriteit (NVWA).
2. Economische en wetenschappelijke impact
- Beschrijf dat bedrijven in het bio-life science park werkgelegenheid en economische groei genereren.
- Benoem dat sommige onderzoeken zonder dierproeven niet mogelijk zijn volgens de huidige wetenschappelijke standaarden (bijvoorbeeld bij de ontwikkeling van geneesmiddelen en vaccins).
3. Wat kan de gemeente wél doen?
- Stimuleren van alternatieven voor dierproeven:
Subsidies of stimuleringsfondsen voor bedrijven die werken aan alternatieven, zoals in-vitro testen en computermodellen.
Samenwerking aangaan met universiteiten of kennisinstituten die werken aan de vervanging, vermindering en verfijning van dierproeven (3V-principe). - Voorwaarden stellen bij nieuwe vestigingen:
Bij het verlenen van omgevingsvergunningen kan de gemeente bedrijven stimuleren om zoveel mogelijk alternatieve testmethoden te gebruiken.
Een opdracht om voor jezelf uit te werken
Hoe sta je zelf tegenover de inzet van dieren voor het doen van proeven voor medisch onderzoek? En hoe ervaar je wet- en regelgeving hierover? Met name over het niet hebben van een rol in controle, handhaving, ed maar wel dat dergelijke onderzoeken in jouw gemeente worden uitgevoerd en daar vragen over komen vanuit inwoners.
Je hoeft deze uitwerking niet in te sturen als huiswerk.
